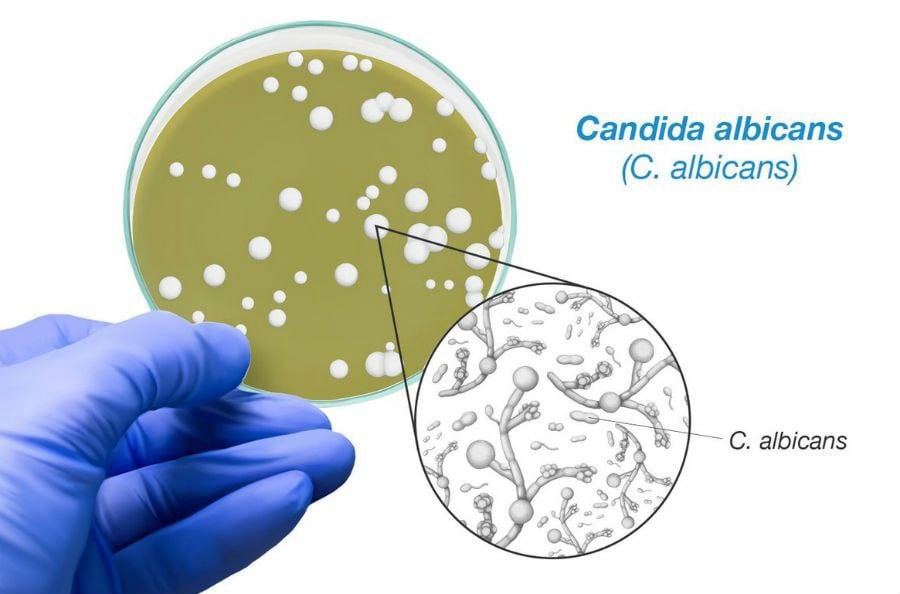
Candida

Αιμορροΐδες
Οι αιμορροΐδες είναι φλέβες που βρίσκονται στο πεπίκλαστρο ή στον πρωκτικό περιοχή και μπορεί να προκαλέσουν διάφορα συμπτώματα. Οι κύριοι παράγοντες που συμβάλλουν στην εμφάνιση αιμορροΐδων περιλαμβάνουν την πίεση στις φλέβες του πεπίκλαστρου, που μπορεί να προκαλείται από διάφορους λόγους, όπως:
Χρόνια δυσκοιλιότητα ή διάρροια: Η δυσκοιλιότητα και η διάρροια μπορεί να οδηγήσουν σε πίεση στον πρωκτικό περιβάλλον.
Καθιστική ζωή: Η μακρά καθιστική στάση μπορεί να αυξήσει την πίεση στις φλέβες του πεπίκλαστρου.
Εγκυμοσύνη και τοκετός: Η εγκυμοσύνη και ο τοκετός μπορούν να προκαλέσουν αυξημένη πίεση στο πεπίκλαστρο.
Ηλικία: Ο μεγάλος αριθμός χρόνων μπορεί να αυξήσει τον κίνδυνο εμφάνισης αιμορροΐδων.
Κληρονομικότητα: Οι γενετικοί παράγοντες μπορούν να παίξουν ρόλο στην εμφάνιση αιμορροΐδων.
Οι κοινές συμπτώματα αιμορροΐδων περιλαμβάνουν πόνο, κνίδωση, φουσκώματα, και αιμορραγία κατά τη διάρκεια της καθημερινής κίνησης ή της αποφόρτισης. Η θεραπεία μπορεί να περιλαμβάνει αλλαγές στον τρόπο ζωής, φαρμακευτικές θεραπείες ή, σε ορισμένες περιπτώσεις, χειρουργική επέμβαση. Εάν υποψιάζεστε ότι έχετε αιμορροΐδες ή αν αντιμετωπίζετε σχετικά συμπτώματα, συμβουλευτείτε τον ιατρό σας για έγκαιρη διάγνωση και θεραπεία.
 Η αιμοχρωμάτωση αναφέρεται στην παρουσία αίματος στα καλυμμένα με καλλυντικά, τα ένδυμα, τα προϊόντα περιποίησης ή άλλα αντικείμενα. Συνήθως, αναφέρεται στην εμφάνιση αίματος σε εξωτερικές επιφάνειες, εκτός του σώματος, που μπορεί να προέρχεται από τραυματισμούς, πληγές, ή άλλες παθήσεις.
Η αιμοχρωμάτωση αναφέρεται στην παρουσία αίματος στα καλυμμένα με καλλυντικά, τα ένδυμα, τα προϊόντα περιποίησης ή άλλα αντικείμενα. Συνήθως, αναφέρεται στην εμφάνιση αίματος σε εξωτερικές επιφάνειες, εκτός του σώματος, που μπορεί να προέρχεται από τραυματισμούς, πληγές, ή άλλες παθήσεις.

















 Η ηπατίτιδα Α είναι μια φλεγμονώδη νόσος του ήπατος που προκαλείται από τον ιό της ηπατίτιδας Α (Hepatitis A virus – HAV). Ο ιός μεταδίδεται κυρίως μέσω μολυσμένου νερού ή τροφών, ειδικά όταν δεν τηρούνται καλές υγειονομικές συνθήκες.
Η ηπατίτιδα Α είναι μια φλεγμονώδη νόσος του ήπατος που προκαλείται από τον ιό της ηπατίτιδας Α (Hepatitis A virus – HAV). Ο ιός μεταδίδεται κυρίως μέσω μολυσμένου νερού ή τροφών, ειδικά όταν δεν τηρούνται καλές υγειονομικές συνθήκες.
 Η ηπατίτιδα Β είναι μια φλεγμονώδη νόσος του ήπατος που προκαλείται από τον ιό της ηπατίτιδας Β (Hepatitis B virus – HBV). Ο ιός μεταδίδεται κυρίως μέσω του αίματος, του σπέρματος, του εκδοράς του τραχήλου της μήτρας και άλλων σωματικών υγρών.
Η ηπατίτιδα Β είναι μια φλεγμονώδη νόσος του ήπατος που προκαλείται από τον ιό της ηπατίτιδας Β (Hepatitis B virus – HBV). Ο ιός μεταδίδεται κυρίως μέσω του αίματος, του σπέρματος, του εκδοράς του τραχήλου της μήτρας και άλλων σωματικών υγρών.
 Η ηπατίτιδα C είναι μια φλεγμονώδη νόσος του ήπατος που προκαλείται από τον ιό της ηπατίτιδας C (Hepatitis C virus – HCV). Ο ιός μεταδίδεται κυρίως μέσω του αίματος, συχνά μέσω μολυσμένων βελόνων κατά τη χρήση ηρωίνης, κατά τη διαδικασία του τατουάζ ή του piercing, κατά τη διαδικασία του διαμοιρασμού εξαρτημάτων που χρησιμοποιούνται για το ξύρισμα ή την περιποίηση των νυχιών, καθώς και μεταγγίσεις αίματος.
Η ηπατίτιδα C είναι μια φλεγμονώδη νόσος του ήπατος που προκαλείται από τον ιό της ηπατίτιδας C (Hepatitis C virus – HCV). Ο ιός μεταδίδεται κυρίως μέσω του αίματος, συχνά μέσω μολυσμένων βελόνων κατά τη χρήση ηρωίνης, κατά τη διαδικασία του τατουάζ ή του piercing, κατά τη διαδικασία του διαμοιρασμού εξαρτημάτων που χρησιμοποιούνται για το ξύρισμα ή την περιποίηση των νυχιών, καθώς και μεταγγίσεις αίματος.
Η Candida albicans είναι ένας μικροοργανισμός που ανήκει στην κατηγορία των μυκητών (καντίδες) και είναι υπεύθυνος για την πλειονότητα των περιπτώσεων καντιντίασης ή καντιντίασις. Η καντιντίαση είναι μια μυκητιασική λοίμωξη που μπορεί να επηρεάσει διάφορα μέρη του σώματος, συμπεριλαμβανομένων του δέρματος, του στόματος, των γεννητικών οργάνων και του γαστρεντερικού συστήματος.
Η Candida albicans είναι ένας μικροοργανισμός που ανήκει στην κατηγορία των μυκητών (καντίδες) και είναι υπεύθυνος για την πλειονότητα των περιπτώσεων καντιντίασης ή καντιντίασις. Η καντιντίαση είναι μια μυκητιασική λοίμωξη που μπορεί να επηρεάσει διάφορα μέρη του σώματος, συμπεριλαμβανομένων του δέρματος, του στόματος, των γεννητικών οργάνων και του γαστρεντερικού συστήματος.
 Ο καρκίνος του πάγκρεας είναι μια σοβαρή μορφή καρκίνου που προκύπτει από τα κύτταρα του πάγκρεας, ένοργανου που βρίσκεται στον ανώτερο μέρος της κοιλιάς, πίσω από το στομάχι. Ο καρκίνος του πάγκρεας είναι συχνά δύσκολος στη διάγνωση στα πρώιμα στάδια, και συνήθως διαγιγνώσκεται όταν έχει ήδη εξαπλωθεί.
Ο καρκίνος του πάγκρεας είναι μια σοβαρή μορφή καρκίνου που προκύπτει από τα κύτταρα του πάγκρεας, ένοργανου που βρίσκεται στον ανώτερο μέρος της κοιλιάς, πίσω από το στομάχι. Ο καρκίνος του πάγκρεας είναι συχνά δύσκολος στη διάγνωση στα πρώιμα στάδια, και συνήθως διαγιγνώσκεται όταν έχει ήδη εξαπλωθεί.


 Οι κιρσοί του οισοφάγου είναι επιφανειακές φλέβες που διογκώνονται και επεκτείνονται στον οισοφάγο. Είναι συχνά συνδεδεμένοι με προβλήματα πίεσης στον πυλώρο του στομάχου και την περιοχή του ήπατος, κυρίως σε περιπτώσεις κίρρωσης του ήπατος.
Οι κιρσοί του οισοφάγου είναι επιφανειακές φλέβες που διογκώνονται και επεκτείνονται στον οισοφάγο. Είναι συχνά συνδεδεμένοι με προβλήματα πίεσης στον πυλώρο του στομάχου και την περιοχή του ήπατος, κυρίως σε περιπτώσεις κίρρωσης του ήπατος.




 Η αγγειοπλαστική των λαγονίων, μηριαίων και κνημιαίων αρτηριών αναφέρεται στη χειρουργική επέμβαση που προορίζεται για την αντιμετώπιση αρτηριακών προβλημάτων σε αυτές τις περιοχές. Η διαδικασία συνήθως περιλαμβάνει τη χρήση αγγειοπλαστικών τεχνικών για τη διόρθωση στενώσεων ή αποκλεισμών στις αρτηρίες, με στόχο τη βελτίωση της κυκλοφορίας του αίματος.
Η αγγειοπλαστική των λαγονίων, μηριαίων και κνημιαίων αρτηριών αναφέρεται στη χειρουργική επέμβαση που προορίζεται για την αντιμετώπιση αρτηριακών προβλημάτων σε αυτές τις περιοχές. Η διαδικασία συνήθως περιλαμβάνει τη χρήση αγγειοπλαστικών τεχνικών για τη διόρθωση στενώσεων ή αποκλεισμών στις αρτηρίες, με στόχο τη βελτίωση της κυκλοφορίας του αίματος.








 Η πρωτοπαθής χολική χολαγγειίτιδα (primary biliary cholangitis, PBC), παλαιότερα γνωστή ως πρωτοπαθής χολική κίρρωση (primary biliary cirrhosis), είναι μια χρόνια αυτοάνοση ηπατική πάθηση που επηρεάζει τα χολαγγεία, τα μικρά αγγεία που μεταφέρουν τη χολή από το ήπαρ προς τον εντερικό σωλήνα. Πρόκειται για μια σπάνια αλλά σοβαρή πάθηση.
Η πρωτοπαθής χολική χολαγγειίτιδα (primary biliary cholangitis, PBC), παλαιότερα γνωστή ως πρωτοπαθής χολική κίρρωση (primary biliary cirrhosis), είναι μια χρόνια αυτοάνοση ηπατική πάθηση που επηρεάζει τα χολαγγεία, τα μικρά αγγεία που μεταφέρουν τη χολή από το ήπαρ προς τον εντερικό σωλήνα. Πρόκειται για μια σπάνια αλλά σοβαρή πάθηση.






